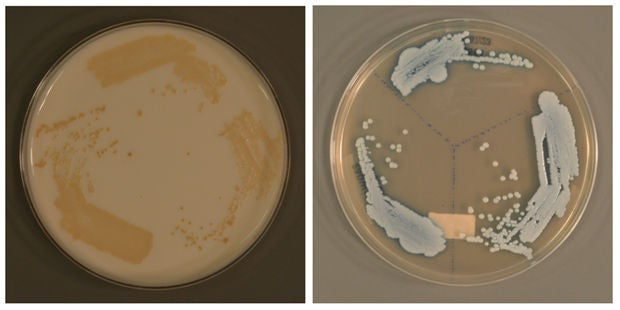

Singapore General Hospital will NEVER ask you to transfer money over a call. If in doubt, call the 24/7 ScamShield helpline at 1799, or visit the ScamShield website at www.scamshield.gov.sg.
We’d love to hear from you! Rate the SGH website and share your feedback so we can enhance your online experience and serve you better. Click here to rate us
Singapore Researchers Discover New Candida auris – A Possible Global Public Health Threat
The novel type of Candida auris grown on different types of culture media. (PHOTO: A*STAR's Genome Institute of Singapore)
MEDIA RELEASE
Singapore, 2 August 2024 – Researchers from the Singapore General Hospital (SGH), A*STAR’s Genome Institute of Singapore (GIS) and Yong Loo Lin School of Medicine at National University of Singapore (NUS Medicine) have discovered a new clade (or type) of Candida auris, bringing the number of clades known globally to a total of six.
Candida auris, or C. auris, is a fungus that is highly transmissible and hard to eradicate. It mostly affects patients with severe underlying medical conditions. Those with invasive medical devices like breathing or feeding tubes and catheters tend to be at higher risk of getting C. auris and developing a range of infections from superficial to more severe, life-threatening ones.
The World Health Organization listed C. auris as a critical priority for research and public health action in 2022. The U.S. Centers for Disease Control and Prevention has also declared the fungus as an ‘urgent antimicrobial resistance threat’ as it has become increasingly difficult to treat, further emphasising the need to understand and mitigate this public health threat.
“The implications of this discovery extend far beyond the laboratory. Now that we have discovered the sixth Candida auris clade, there is a pressing need to improve surveillance capability or develop new methods to augment current surveillance strategies so that healthcare facilities can keep a close watch on its emergence and contain the spread once found,” said Dr Karrie Ko, co-first author of the study. She is also Consultant, Department of Microbiology, SGH, and Genomics Director of the Pathology Academic Clinical Programme under SingHealth and Duke-NUS Medical School.
The new clade was detected in 2023 after an SGH patient tested positive for C. auris, which is commonly associated with overseas travel. The patient, however, had remained in Singapore for two years prior, which prompted further investigations. Scientists from A*STAR’s GIS developed a machine-learning technique to keep track of a potential new C. auris clade. They then reconstructed the C. auris genomes and performed an in-depth characterisation of the genomes to confirm the emergence of a new clade.
Upon discovering that the patient had C. auris belonging to a clade that was genetically different from the other five, the team looked through the Hospital’s archive and found two other patient cases. Their discovery was documented in “Detection and characterisation of a sixth Candida auris clade in Singapore: a genomic and phenotypic study”, which was published in the peer-reviewed medical journal, The Lancet Microbe, in July 2024.
SGH has an active surveillance programme which screens high-risk patients for C. auris through a routine swab upon admission. Patients who are tested positive are immediately isolated and all inpatients who shared the same ward or room will be screened as part of the Hospital’s strategy to contain its spread.
The team is now working on a proof-of-concept machine learning approach that can automatically detect new clades early. This is particularly important for regional hubs like Singapore, which receives high number of international visitors, to monitor and identify emerging public health threats early.
“This study demonstrated that machine learning approach can improve surveillance capabilities by automatically detecting unusual outlier genomes. Our human-in-the-loop machine learning workflow facilitates continuous learning from new data, so that we can detect and investigate potential novel genomes as early as possible. This has the potential to strengthen surveillance against emerging public health threats,” said co-first author of the study, Dr Chayaporn Suphavilai, Senior Scientist, A*STAR’s GIS.
"Genomic surveillance is essential for understanding emerging pathogens. By integrating genomics, metagenomics, and collaborative efforts among researchers and clinicians, we can continually enhance our pandemic preparedness and response to public health threats," said senior author of the study, Associate Professor Niranjan Nagarajan, from the Infectious Diseases Translational Research Programme at NUS Medicine, and Associate Director, Genome Architecture, and Senior Group Leader, Laboratory of Metagenomic Technologies and Microbial Systems at A*STAR’s GIS.
The study was supported by the Duke-NUS Academic Medical Center Nurturing Clinician Researcher Scheme and the Genedant-GIS Innovation Program.

From far left: A/Prof Niranjan Nagarajan, Dr Chayaporn Suphavilai, Dr Karrie Ko,
Ms Tan Mei Gie (SGH) and Ms Lim Kar Mun (A*STAR’s GIS)
(PHOTO: A*STAR's Genome Institute of Singapore)
---
For media enquiries, please contact:
Singapore General Hospital
Carol Ang
Communications Department
Email: carol.ang@sgh.com.sg
A*STAR’s Genome Institute of Singapore
Eliza Lim (Ms)
Senior Manager,
Office of Corporate Communication and Office of Research Planning
Email: Eliza_Lim@gis.a-star.edu.sg
National University of Singapore, Yong Loo Lin School of Medicine
Gladys Sim
Communications
Email: gladyssim@nus.edu.sg

English
Media Release-Singapore Researchers Discover New Candida auris.pdf
Stay Healthy With
Outram Road, Singapore 169608
© 2026 Singapore General Hospital Pte Ltd. All Rights Reserved.



















